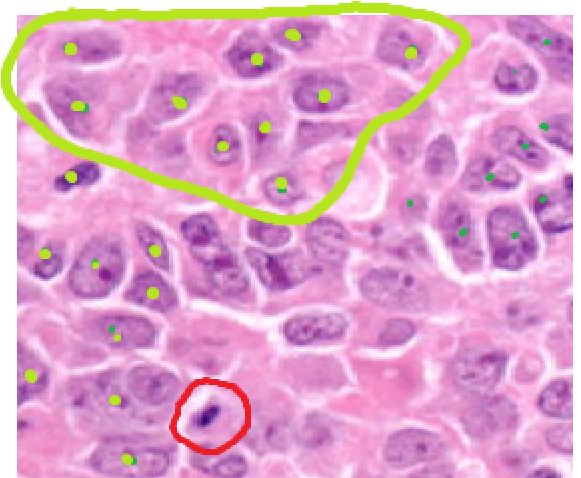

Mitotic index & cancer
In this activity students are first guided through the identification of cells in the different stages of mitosis. Following this, the next task is to count and record the number of cells undergoing mitosis and those which aren't in samples from human breast tissue biopsies. The calculation of the mitotic index is carried out and the results used as a prognostic tool to decide the nature of cells in the samples.
Lesson Description
Guiding Questions
How long does it take a cell to divide?
Is mitosis more rapid in cancer cells than 'normal' cells?
Is interphase shorter in the cell cycle of cancer cells?
Activity 1- Identify the stages of mitosis in human cells
The stages of mitosis in theoretical diagrams of chromosomes are often used to explain the process of mitosis. In real tissue samples the task is more challenging because the alignment of the spindle in metaphase and anaphase can be in any orientation. For example, two groups of dividing chromosomes in anaphase can be visible over the top of each other.
This illustration shows views of anaphase from different perspectives.
Study the shapes of the nuclei in the images below and try to identify which phase of mitosis for each of the cells circled in green. Most of the cells surrounding these highlighted ones are in interphase.

Complete the notes on the
Identifying the stages of mitosis student sheet.
Activity 2: Calculate the mitotic index in two samples of human tissue
A common test for tissue biopsies in cancer care uses visible features of the cells in the tissue. Different types of cancer each have a slightly different system. In breast cancer grading these features include:
- Tubule formation – how much the tissue has a normal structure (because cancer cells do not differentiate properly causing the tissue to lose it's normal structure).
- Nuclear shape variations – cell nuclei look different from small round nuclei of normal cells (because some cancer genes cause changes in nuclear membrane shape and size).
- The number of cells in one of the stages of mitosis (because cancer cells divide more frequently).
The number of cells dividing is used to estimate the mitotic index in human tissue biopsies using the formula:

Calculation of the mitotic index of these cells in cancerous and normal tissues can help to decide how fast growing a cancer is, it can give a prognosis for the patient and help doctors and radiologists decide the best treatment to use.
The red, amber and green samples in the image below show the number of cells in a stage of mitosis (black arrows).
While the occurrence of mitosis is low in a single frame, ten microscope views at high power (x400) are often used to give better reliability, sometimes even more.
Method for calculation of the mitotic index:
- Identify any cells that are in any stage of mitosis. Use a red circle for each.
- Count all the cells in the frame.
Put a dot on each nucleus, circle groups of ten cells, then count the number of groups, plus any remaining cells.
Note: Identifying individual cells is not easy, as there is a variety of shapes and sizes of cells and even nuclei. Count quite quickly, without letting an occasional unclear cell slow down the process too much. Remember the cell count is an estimation and a total count of 145 or 146 will make little different to the mitotic index; 7/145 is almost the same as 7/146.
- Record the number of cells in mitosis and the total number of cells.
- Then calculate the mitotic index as a decimal and a %.
Complete the calculations of mitotic index on this
Mitotic index activity with two samples student worksheet.
Activity 3 - Extension reading about cytokinesis
Cytokinesis is essential to complete the cell cycle and divide a cell into two cells following mitosis. The details of the mechanisms are not required in detail for the IBDP Biology programme, but the way that it is different in plant and animal cells is required.
Read the following extract from the excellent cell biology text book, Essential Cell Biology by Bruce Alberts, Karen Hopkin, Alexander D. Johnson, David Morgan and Martin Raff
As you read make a table of comparisons between cytokinesis in plant and animal cells
Teachers' notes
Activity 1 Recognising mitosis - Students are first guided through the identification of cells in different stages of mitosis. It is important that students have a basic reference document for the stages of mitosis, as this activity builds on the simple and clear explanations of chromosome movements during mitosis.
The slide shows 12 different views of human cells performing mitosis taken from biopsy sample of breast tissue. It is normal that there is some doubt in the identification of these cells, real pathologists must also find this difficult.
Model answers can be found on this page: Identifying stages of mitosis - model answers (access to this page can be controlled in the Student access area) and in the slides on the model answers page I have sketched a diagram of each cell, to try to show the process of identification of the stage of mitosis. Of course, just like real pathologists, your intermretation may be different from mine, but the slides were originally identified in this research paper, Evaluation of Mitotic Activity Index in Breast Cancer Using Whole Slide Digital Images, published 30 Dec 2013 PLOS ONE
The student's worksheet asks the students to suggest an identification of the phase of mitosis. The command term suggest is used when there is an element of doubt about the interpretation of data, so this may be a good opportunity to alert students to this possible which doesn occur occasionally in IB DP Biology exams. It is also an opportunity to make a link to TOK, because the reliability of scientific data does depend on human interpretation.
Activity 2 Mitotic index - Students use their understanding of mitosis in cell tissue to estimate the Mitotic index. Hospitals use this index together with other qualitative data to grade cancer tissue from biopsies. There are two sets of five slides for students to identify cells undergoing mitosis. The method can be projected from the page, and the worksheet used to record the notes. Counting the cells is a bit of an art, and it may be worth explaining that this is an estimation. There are a few questions in this sheet which illustrate the use of the mitotic index as a prognostic tool, as a histologist or a doctor might do.
To estimate the mitotic index.
- Count the cells in each of the slides individually and record the numbers in the table on the worksheet.
- For increased reliability add together the totals for cells A to E - these cells are all from one sample,
- Cells F to J are from a second sample so repeat the calculation for these cells.
Activity 3 - Extension reading.
The IB Bio guide mentions cytokinesis and this whole activity has looked at mitosis without a mention of cytokinesis. This reading puts this right. Although the text is from a university text book the details are all related to organelles in the cell and the differences between plant and animal cells. This is a great link back to cell structure and one of the key differences between plant and animal eukaryotic cells.
Students are asked to make a table showing comparisons between plant and animal cytokinesis. This activity will hep students to record useful notes from the reading, without having to write an essay!
Alternative ideas
Some classes may wish to try the technique on prepared slides of onion or garlic root tip cells as an extension activity.
If a wet lab is also wanted there are some good resources Mitotic index experiments on this website.
These ideas look great for building models to illustrate the cell cycle and mitosis. Cell cycle on a plate, and using wool in mitosis diagrams. (Images borrowed from Mrs Stevens' Science classes blog )
Onion or Garlic root tip experiments
The cells in an onion root can quite easily be used to calculate the mitotic index and this is a good learning exercise. The cell outline in plant cells is much clearer than it is in human cells. The onions, or garlic can be grown in the lab, Allium species is mentioned in the speciation section of genetics because they illustrate cases of speciation by polyploidy. However diagnosis of cancer in onion roots is one step further away from learning about the actual clinical value of the mitotic index.
Legacy link to the old student worksheet
Cancer and the cell cycle - student worksheet
and the Mitotic index worksheet - model answers for the two conclusion questions
IB Docs (2) Team

